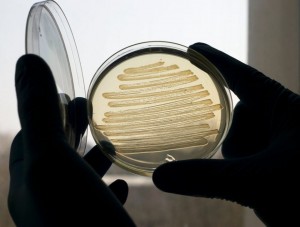

Это не научная фантастика. Группа исследователей из Эксетерского университета (Великобритания), работавшая при поддержке компании Shell, заставила бактерии E. coli (кишечная палочка) вырабатывать дизельное топливо.
Это не научная фантастика. Группа исследователей из Эксетерского университета (Великобритания), работавшая при поддержке компании Shell, заставила бактерии E. coli (кишечная палочка) вырабатывать дизельное топливо.
Такое топливо по своим характеристикам практически идентично дизельному топливу, полученному из нефти и, в отличие от обычного биодизеля, не потребует смешивания с нефтепродуктами прежде чем попасть в бак автомобиля. Это означает, что его можно будет использовать без модернизации автомобильных двигателей, хранилищ топлива, трубопроводов и прочей инфраструктуры.
По словам профессора Эксетерского университета Джона Лава (John Love), получение биотоплива, пригодного для использования транспортными средствами без какой-либо их модернизации, было изначальной целью проекта. Замена обычного дизельного топлива биотопливом в коммерческих масштабах может стать серьезным шагом к достижению цели сокращения выбросов парниковых газов на 80% к 2050 году. В условиях глобального роста спроса на энергию появление топлива, цена которого не зависит от колебаний цен на нефть и политической стабильности, является очень заманчивой перспективой.
Бактерии E. Coli широко используются в различных целях в промышленной микробиологии. В естественных условиях эти бактерии перерабатывают сахара в жиры, из которых формируют свои клеточные мембраны. Этот же процесс может быть использован для синтеза жиров в производстве биотоплива. Новый биодизель пока получен только в лаборатории в мизерных количествах, но исследователи надеются, что разработанная ими технология сможет проложить себе путь к промышленному использованию.
